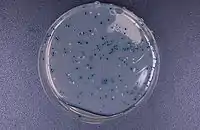

X-gal
X-Gal, também conhecida como 5-bromo-4-cloro-3-indoxil-β-D-galactopiranosídeo é um glicosídeo artificial análogo à lactose e um substrato cromógeno para a enzima β-galactosidase.[1]
| X-gal Alerta sobre risco à saúde | |
|---|---|
 | |
| Nome IUPAC | 5-bromo-4-cloro-3-indoxil-β-D-galactopiranosídeo |
| Identificadores | |
| Número CAS | |
| PubChem | |
| ChemSpider | |
| MeSH | |
| ChEBI | |
| SMILES |
|
| InChI | 1/C14H15BrClNO6/c15-5-1-2-6-9(10(5)16)7(3-17-6)22-14-13(21)12(20)11(19)8(4-18)23-14/h1-3,8,11-14,17-21H,4H2/t8-,11+,12+,13-,14-/m1/s1 |
| Propriedades | |
| Fórmula molecular | C14H15BrClNO6 |
| Massa molar | 408.629 |
| Página de dados suplementares | |
| Estrutura e propriedades | n, εr, etc. |
| Dados termodinâmicos | Phase behaviour Solid, liquid, gas |
| Dados espectrais | UV, IV, RMN, EM |
| Exceto onde denotado, os dados referem-se a materiais sob condições normais de temperatura e pressão Referências e avisos gerais sobre esta caixa. Alerta sobre risco à saúde. | |
Propriedades
A enzima β-galactosidase hidrolisa X-Gal, formando galactose e 5-bromo-4-cloro-3-indoxil. O 5-bromo-4-cloro-3-indoxil]] na presença de oxigênio do ar é oxidado e convertido no corante azul 5,5'-dibromo-4,4'-dicloro-índigo.

Aplicações
Na bioquímica, o X-Gal é utilizado para medição qualitativa da atividade da β-galactosidase benutzt. Para medição quantitativa é utilizado, por sua vez, o substrato o-Nitrofenil-β-D-galactopiranosídeo (ONPG).
Na biologia molecular o X-Gal é utilizado para triagem azul-branca (blue-White screening). Em diversos vetores de clongem, um "sítio de clonagem múltipla" (Multiple Cloning Site) está presente no meio da sequência codificadora do fragmento α (parte N-terminal) da β-galactosidase. Nesse sítio é possível colocar DNA exógeno de interesse, como fragmentos provenientes de PCR. Com isso, a sequência da β-galactosidase é quebrada somente nas células transformadas com vetor contendo o inserto (DNA exógeno de interesse, que passam a não expressar mais a enzima. Disso segue-se que essas células não poderão mais clivar a X-Gal, não produzindo produto azul. Nesse processo de transformação, as colônias sem o fragmento exógeno inserido no vetor aparecerão em azul, enquanto as brancas (com o DNA de interesse) aparecerão brancas.
A X-Gal é utilizado normalmente em conjunto com IPTG (um indutor do promotor lac, veja também operon lac), para a triagem das colônias azuis. Ele é utilizado também para aferir a atividade de β-galactosidase como gene repórter.[2] em transfecções de células eucarióticas e para detecção de β-galactosidase em ensaios de histoquímica.
Outros substratos cromógenos:
- 5-bromo-3-indolil-β-D-galactopiranosídeo (Blue-Gal, Bluo-Gal)
- 6-cloro-3-indolil-β-D-galactopiranosídeo (Y-Gal, Red-Gal, Rose-Gal, Salmon-Gal)
- 5-iodo-3-indolil-β-D-galactopiranosídeo (Purple-Gal)
- 5-bromo-6-cloro-3-indolil-β-D-galactopiranosídeo (Magenta-Gal)
- N-Metilindolil-β-D-galactopiranosídeo (Green-Gal)
Outros substratos fluorógenos:
- 4-Metil-umbeliferil-β-D-galactopiranosíeo (MUG) (λex = 365 nm, λem = 455 nm)
Ver também
- X-Gluc
- X-Phos
Referências
- Kiernan JA 2007. Indigogenic substrates for detection and localization of enzymes. Biotechnic & Histochemistry 82(2): 73-103.
- Sandhu, Sardul Singh (2010). Recombinant DNA Technology. [S.l.]: I K International Publishing House. p. 116. ISBN 978-9380578446
Leitura adicional
- Sambrook, J.; Maniatis, T.; Russel, D.W. : Molecular cloning: a laboratory manual. Cold Spring Harbor Laboratory Press; 3rd edition (2001) ISBN 0-87969-577-3.
- Horwitz, J.P. et al. (1964). Substrates for Cytochemical Demonstration of Enzyme Activity. I. Some Substituted 3-Indolyl-β-D-glycopyranosides. J Med Chem. 7(4), S. 574–575; doi:10.1021/jm00334a044.
- Edwards, M.J., and Taylor, M.F. (1993). Substitution of DMSO for DMF as a Solvent for X-Gal. BioTechniques, 14, S. 234.